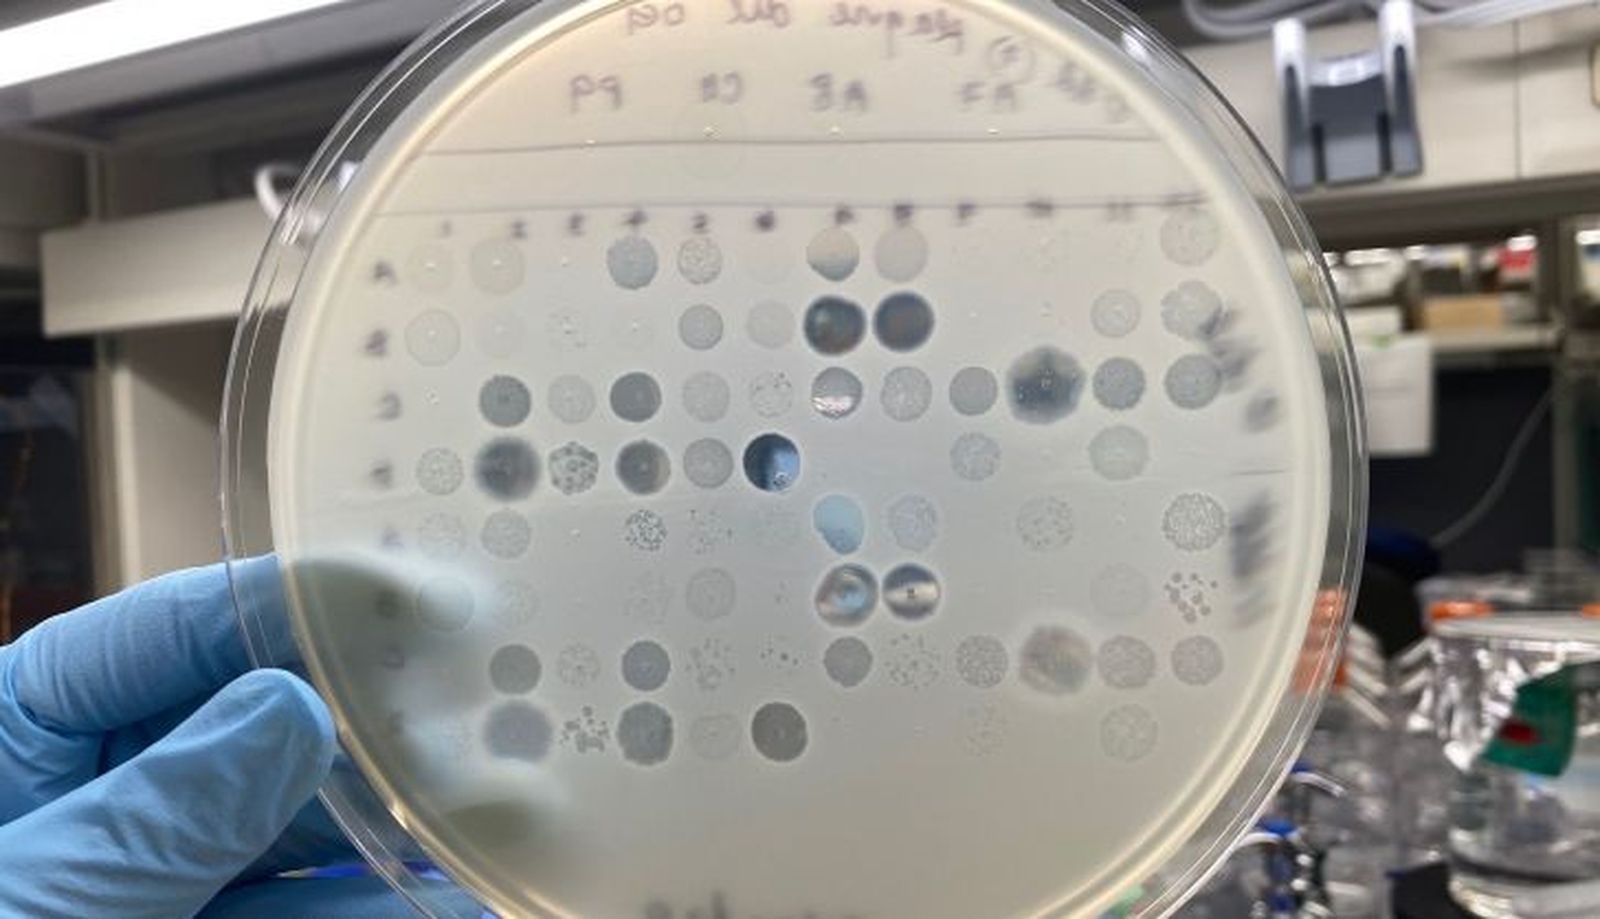
53688

El Instituto de Biología Funcional y Genómica de Salamanca participa en un estudio que permite avanzar contra el problema de las resistencias bacterianas a los antibióticos
La investigación, que Sánchez inició en la Universidad de Yale (Estados Unidos) y que siguió liderando tras su incorporación al IBFG junto con Kevin Foster, de la Universidad de Oxford (Reino Unido), está centrada en una cepa genéticamente uniforme de Escherichia coli, una bacteria que coloniza el intestino humano y puede causar enfermedades graves

Un estudio internacional publicado en la prestigiosa revista Science demuestra que diversas especies de virus bacteriófagos, conocidos como fagos, pueden coexistir en una misma cepa de bacterias. Este hallazgo, en el que ha participado Álvaro Sánchez, investigador del Instituto de Biología Funcional y Genómica (IBFG, centro mixto del CSIC y la Universidad de Salamanca), tiene una enorme relevancia porque este tipo de virus ataca a las bacterias y, por lo tanto, se están planteando como posible tratamiento frente a las cepas que se han vuelto resistentes a los antibióticos.
La investigación, que Sánchez inició en la Universidad de Yale (Estados Unidos) y que siguió liderando tras su incorporación al IBFG junto con Kevin Foster, de la Universidad de Oxford (Reino Unido), está centrada en una cepa genéticamente uniforme de Escherichia coli, una bacteria que coloniza el intestino humano y puede causar enfermedades graves. En contra de lo que se pensaba anteriormente, los autores han comprobado que varias especies de fagos pueden infectar de manera estable células bacterianas que son idénticas. “Los bacteriófagos son muy distintos a los virus humanos, tienden a ser más pequeños, aunque, curiosamente, tienen un genoma más grande”, afirma el investigador en declaraciones a DiCYT. Las estrategias que utilizan para atacar a las bacterias son diversas. Algunos “se integran en el genoma de la bacteria y se replican con ella”. Otros, en cambio, “entran en la célula bacteriana y se multiplican hasta hacerla explotar, dispersándose para alcanzar otras células”, comenta. La novedad que revela este estudio es que varios de estos fagos puedan coexistir a costa de una misma cepa bacteriana.
Depredadores especializados
Aunque se conocía que la diversidad de fagos es mayor que la de las propias bacterias, en general, “en ecología se considera difícil que dos depredadores puedan coexistir atacando a la misma presa, salvo raras excepciones”, explica el experto. En este caso, los depredadores son los virus y, normalmente, “hay uno que excluye al resto porque se replica más rápido, se queda con todas las células e impide que otros virus prosperen, llevándolos a la extinción”.
Sin embargo, después de realizar decenas de experimentos con una misma cepa de E. coli, los científicos comprobaron que al menos dos virus coexistían siempre de forma estable. La explicación es que los distintos fagos se especializan en células que, aunque son genéticamente iguales, no son fenotípicamente iguales, es decir, “no se comportan de la misma manera”. Por ejemplo, sus patrones de crecimiento pueden ser diferentes, más rápidos o lentos, algo que determina el azar. Los virus aprovechan esa diferencia para repartirse, “unos se especializan en las células que crecen un poco más rápido y otros, en las más lentas”. Así, son capaces de coexistir porque no hay una competencia directa entre ellos.
Hacia los cócteles de fagos contra bacterias
El artículo publicado en Science puede ofrecer nuevas pistas para afrontar el problema de las resistencias a los antibióticos. Algunas bacterias se están haciendo resistentes a estos fármacos, convirtiéndose en un grave problema de salud pública. Muchos científicos se plantean usar fagos para acabar con ellas, pero hasta ahora ninguna terapia basada en estos virus ha llegado a convertirse en un tratamiento estándar. El problema suele ser que un solo fago no consigue matar todas las bacterias o que estas también logran evolucionar para hacerse resistentes, como pasa con los antibióticos tradicionales. La solución estaría en crear cócteles que incluyan distintos fagos, pero hasta ahora esta solución ofrecía poca confianza por la tendencia a eliminarse entre sí.
Sin embargo, ahora “nuestro estudio sugiere que el diseño de cócteles de fagos capaces de coinfectar a las bacterias puede ser más exitoso de lo que se había pensado”, asegura el investigador del IBFG. Los científicos temían que alguno de los virus se extinguiera y el cóctel no funcionase bien, pero ahora saben que “la coexistencia entre ellos puede ser más sencilla de lo que se pensaba”. Además, los experimentos ofrecen datos que permiten encontrar los fagos que puedan coexistir. La idea es “identificar las mejores combinaciones”, resume.
También te puede interesar
Lo último








